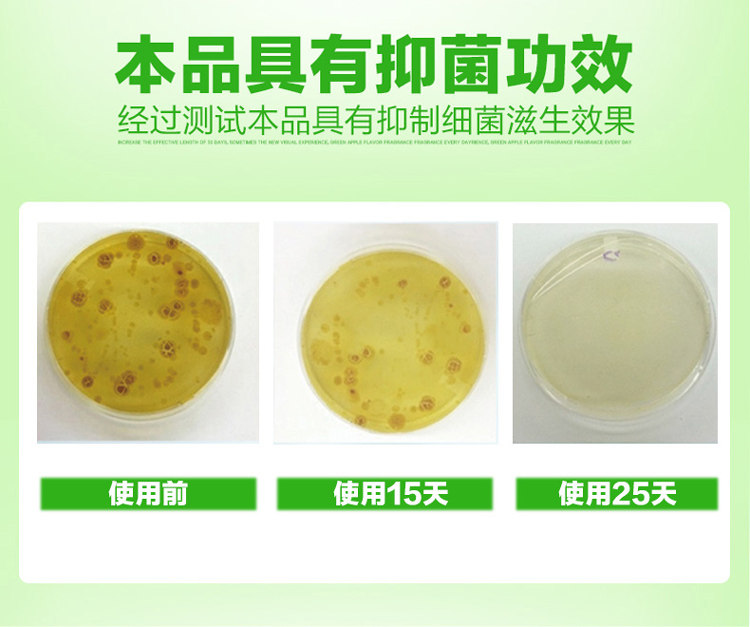

- Таобао
- Все для ванной и туалета
- Ершики для унитаза
- 632284793135
Дезодорант, гигиенический туалет, чистящее средство, ароматное моющее средство для домашнего использования

Цена: 271руб. (¥12.8)
Артикул: 632284793135
Вес товара: ~0.7 кг. Указан усредненный вес, который может отличаться от фактического. Не включен в цену, оплачивается при получении.
Описание товараPGRpdj48YSBuYW1lPSJjeGJfR2lmdF8xXzE3MjgxMl9iZWdpbiIgc3R5bGU9ImZvbnQtc2l6ZTogMDtoZWlnaHQ6IDA7Ij48L2E+PC9kaXY+PGRpdiBzdHlsZT0iZm9udC1mYW1pbHk6IG1pY3Jvc29mdCB5YWhlaTtmb250LXNpemU6IDE0LjBweDttYXJnaW46IDAgYXV0bztvdmVyZmxvdzogaGlkZGVuO3BhZGRpbmc6IDA7dGV4dC1hbGlnbjogbGVmdDt3aWR0aDogYXV0bzsiPjxpbWcgc3JjPSJodHRwczovL2ltZy5hbGljZG4uY29tL2ltZ2V4dHJhL2kzLzIyMDY5NTk0Mjg3MzcvTzFDTjAxUjlrMXpqMkVQYjRER0psVGpfISEyMjA2OTU5NDI4NzM3LnBuZyI+PC9kaXY+PGRpdiBzdHlsZT0ibWFyZ2luLWJvdHRvbTogNS4wcHg7Ij48YSBuYW1lPSJjeGJfR2lmdF8xXzE3MjgxMl9lbmQiIHN0eWxlPSJmb250LXNpemU6IDA7aGVpZ2h0OiAwOyI+PC9hPjwvZGl2PjxwPjxicj5cPGltZyBhbGlnbj0iYWJzbWlkZGxlIiBzcmM9Imh0dHBzOi8vaW1nLmFsaWNkbi5jb20vaW1nZXh0cmEvaTIvMjIwNjk1OTQyODczNy9PMUNOMDFYbWRWOGUyRVBiNERWVFJqNV8hITIyMDY5NTk0Mjg3MzcuanBnIiBzdHlsZT0iIj48aW1nIGFsaWduPSJhYnNtaWRkbGUiIHNyYz0iaHR0cHM6Ly9pbWcuYWxpY2RuLmNvbS9pbWdleHRyYS9pMy8yMjA2OTU5NDI4NzM3L08xQ04wMTUyTGhkMjJFUGI0OWJ0TDJBXyEhMjIwNjk1OTQyODczNy5qcGciIHN0eWxlPSIiPjxpbWcgYWxpZ249ImFic21pZGRsZSIgc3JjPSJodHRwczovL2ltZy5hbGljZG4uY29tL2ltZ2V4dHJhL2kyLzIyMDY5NTk0Mjg3MzcvTzFDTjAxRmg5M3U2MkVQYjRDRmhKRUVfISEyMjA2OTU5NDI4NzM3LmdpZiIgd2lkdGg9Ijc5MCIgc3R5bGU9IiI+PGltZyBhbGlnbj0iYWJzbWlkZGxlIiBzcmM9Imh0dHBzOi8vaW1nLmFsaWNkbi5jb20vaW1nZXh0cmEvaTEvMjIwNjk1OTQyODczNy9PMUNOMDFIZWRCN2MyRVBiNDdhSThJYl8hITIyMDY5NTk0Mjg3MzcuanBnIiB3aWR0aD0iNzkwIiBzdHlsZT0iIj48aW1nIGFsaWduPSJhYnNtaWRkbGUiIHNyYz0iaHR0cHM6Ly9pbWcuYWxpY2RuLmNvbS9pbWdleHRyYS9pMy8yMjA2OTU5NDI4NzM3L08xQ04wMWR0NG5CRzJFUGI0M3VyeEdKXyEhMjIwNjk1OTQyODczNy5qcGciIHN0eWxlPSIiPjxpbWcgYWxpZ249ImFic21pZGRsZSIgc3JjPSJodHRwczovL2ltZy5hbGljZG4uY29tL2ltZ2V4dHJhL2kzLzIyMDY5NTk0Mjg3MzcvTzFDTjAxUExPNmpWMkVQYjQ1YXFIOW5fISEyMjA2OTU5NDI4NzM3LmpwZyIgc3R5bGU9IiI+PGltZyBhbGlnbj0iYWJzbWlkZGxlIiBzcmM9Imh0dHBzOi8vaW1nLmFsaWNkbi5jb20vaW1nZXh0cmEvaTIvMjIwNjk1OTQyODczNy9PMUNOMDFNcGhuY3UyRVBiNDN1czlqUV8hITIyMDY5NTk0Mjg3MzcuanBnIiBzdHlsZT0iIj48aW1nIGFsaWduPSJhYnNtaWRkbGUiIHNyYz0iaHR0cHM6Ly9pbWcuYWxpY2RuLmNvbS9pbWdleHRyYS9pMS8yMjA2OTU5NDI4NzM3L08xQ04wMVpYSDdBUjJFUGI0NTVXMFd2XyEhMjIwNjk1OTQyODczNy5qcGciIHN0eWxlPSIiPjxpbWcgYWxpZ249ImFic21pZGRsZSIgc3JjPSJodHRwczovL2ltZy5hbGljZG4uY29tL2ltZ2V4dHJhL2kzLzIyMDY5NTk0Mjg3MzcvTzFDTjAxZFJGYmQzMkVQYjQ4Vzh3OXFfISEyMjA2OTU5NDI4NzM3LmpwZyIgc3R5bGU9IiI+PGltZyBhbGlnbj0iYWJzbWlkZGxlIiBzcmM9Imh0dHBzOi8vaW1nLmFsaWNkbi5jb20vaW1nZXh0cmEvaTEvMjIwNjk1OTQyODczNy9PMUNOMDE2UXhuTUYyRVBiNENGaFJaa18hITIyMDY5NTk0Mjg3MzcuanBnIiB3aWR0aD0iNzkwIiBzdHlsZT0iIj48L3A+PGRpdiBzdHlsZT0iaGVpZ2h0OiAwO3dpZHRoOiAwO2ZvbnQtc2l6ZTogMDsiPtCc0L7QtNGD0LvRjCDQvtC/0LjRgdGL0LLQsNC10YIg0YLQtdC60YHRgiwg0LfQsNC90Y/RgtGL0Lk8L2Rpdj4=
Продавец:智瑾家居专营店
Адрес:Синьцзян
Рейтинг:

Всего отзывов:0
Положительных:0
Добавить в корзину